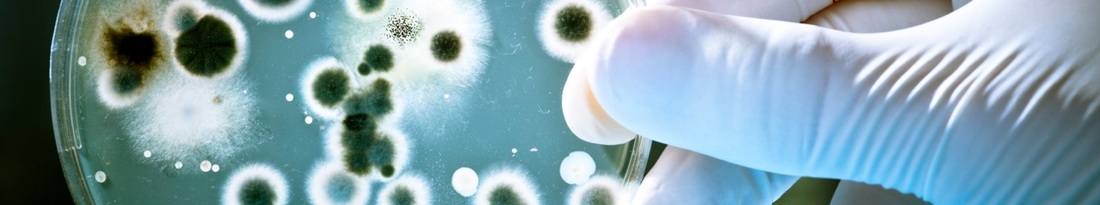
Picture

Manufacturers
|
Feed attractants
Attractants and taste enhancers are core business for INNOVAD... |
|
Antibacterials
& Feed Preservatives The choice of raw materials and their sustainable quality are the keys... |